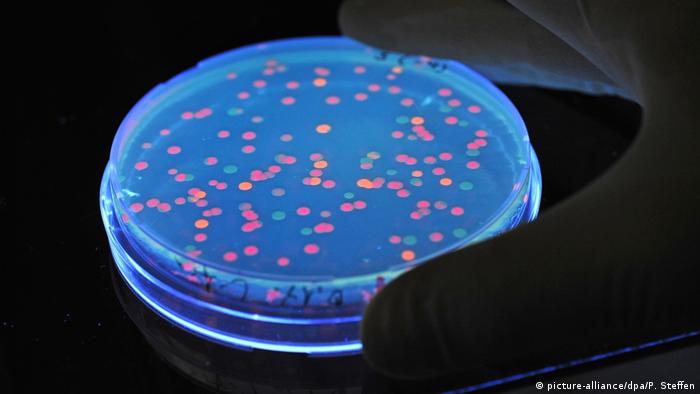
Бактериите от групата Salmonella живеят в стомашно-чревния тракт на доста животни. Но за индивида ентеробактериите постоянно водят до тежки болести. Строгото съблюдаване на разпоредбите за хигиена в кухнята, както и топлинната обработка (15 минути са достатъчно) най-много на месните и рибните артикули оказват помощ да се избегне разпространяването на салмонелите.

Какво трябва да знаем за бактериите в храните
Може ли да консумираме немити зеленчуци? А храни, които са леко мухлясали? Какво би трябвало да знаем, когато подготвяме месо? И по какъв начин да избегнем разпространението на бактерии в кухнята? Отговорите - в нашата фотогалерия:
 Какво би трябвало да знаем за бактериите в хранитеАфлатоксините - отровата от плесенните гъби
Какво би трябвало да знаем за бактериите в хранитеАфлатоксините - отровата от плесенните гъби Някои типове микроскопични гъби от групата Aspergillus създават извънредно рискови отрови - най-силните от всички биологични токсини. Плесенните гъби се появяват всекидневно по орехите и другите ядки, по зърнените култури като царевица и жито, по семената. Ако в кухнята ви има мухлясали храни - даже и единствено частично, най-добре ги изхвърлете.
 Какво би трябвало да знаем за бактериите в хранитеСмъртоносната мухъл
Какво би трябвало да знаем за бактериите в хранитеСмъртоносната мухъл Дори и в дребни дози приемането на афлатоксини може да аргументи съществени болести - като рак на черния дроб, или пък да докара до нарушавания в развиването на плода в майчината вътрешност. Високата централизация на този токсин провокира остро отравяне, нерядко с летален излаз.
 Какво би трябвало да знаем за бактериите в хранитеСалмонелите
Какво би трябвало да знаем за бактериите в хранитеСалмонелите Бактериите от групата Salmonella живеят в стомашно-чревния тракт на доста животни. Но за индивида ентеробактериите постоянно водят до тежки болести. Строгото съблюдаване на разпоредбите за хигиена в кухнята, както и топлинната обработка (15 минути са достатъчно) най-много на месните и рибните артикули оказват помощ да се избегне разпространяването на салмонелите.
 Какво би трябвало да знаем за бактериите в хранитеОпасните чревни пръчици
Какво би трябвало да знаем за бактериите в хранитеОпасните чревни пръчици От една страна бактериите от групата Escherichia coli извършват значими функционалности в червата на индивида. Но при хората с отслабена имунна система изключително рисковият високопатогенен вариант на пръчковидните бактерии (ентерохеморагична ешерихия коли) може да провокира тежка чревна зараза.
 Какво би трябвало да знаем за бактериите в хранитеКоварната салата
Какво би трябвало да знаем за бактериите в хранитеКоварната салата Високата температура може да унищожи и салмонелите, и чревните причици. За страдание обаче бактерии има освен в продуктите от скотски генезис, само че и в зеленчуците. Преди приложимост марулите, краставиците и всички останали зеленчуци би трябвало деликатно да се измият с топла вода. Важно е да се употребяват разнообразни ножове за зеленчуци и месо. Това оказва помощ за понижаване на риска от болест.
 Какво би трябвало да знаем за бактериите в хранитеЛистериите
Какво би трябвало да знаем за бактериите в хранитеЛистериите Пръчковидните бактерии от групата Listeria са известни със способността си да се приспособяват съвършено. Те в действителност са на всички места, в това число в питателните артикули. В организма на индивида те са способни да провокират заразяване на кръвта или менингит (възпаление на кората на основния мозък). Листериите могат да бъдат победени посредством термична обработка - на 70 градуса за минимум 10 минути.
 Какво би трябвало да знаем за бактериите в хранитеНоровирусът
Какво би трябвало да знаем за бактериите в хранитеНоровирусът Вирусът Норовирус или Норфолк от групата на норовирусите доста постоянно е провинен за разпространяването на " стомашното разстройство " с гадене, повръщане и диария. Вирусът може да живее до 12 дни по зеленчуците и месните артикули. Борбата с него се води още веднъж посредством термичната обработка и дезинфекцията на ръцете.
 Какво би трябвало да знаем за бактериите в хранитеЧистите ръце - залог за здраве
Какво би трябвало да знаем за бактериите в хранитеЧистите ръце - залог за здраве Хранителните артикули влизат в прикосновение с микробите още до момента в който се обработват. Най-вече в личната кухня. Затова спазването на хигиената е най-хубавият метод за битката с бактериите и вирусите. Най-важното е ръцете да бъдат измити деликатно със сапун, преди да се пристъпи към приготвянето на храната.
 Какво би трябвало да знаем за бактериите в хранитеЗлатните правила на кухненската хигиена
Какво би трябвало да знаем за бактериите в хранитеЗлатните правила на кухненската хигиена След като един път сте размразили артикули, не трябва да ги замразявате отначало. За рязането на месото, рибата и зеленчуците би трябвало да се употребяват разнообразни дъски - по този начин може да се предотврати преместването на бактериите към продуктите, които не изискват термична обработка. Месото и рибата би трябвало да се готвят не по-малко от 10 минути (на не по-малко от 70 градуса) и би трябвало да се изяждат още същия ден!
Автор: Инга Ванер, София Вагнер
 Какво би трябвало да знаем за бактериите в хранитеАфлатоксините - отровата от плесенните гъби
Какво би трябвало да знаем за бактериите в хранитеАфлатоксините - отровата от плесенните гъби Някои типове микроскопични гъби от групата Aspergillus създават извънредно рискови отрови - най-силните от всички биологични токсини. Плесенните гъби се появяват всекидневно по орехите и другите ядки, по зърнените култури като царевица и жито, по семената. Ако в кухнята ви има мухлясали храни - даже и единствено частично, най-добре ги изхвърлете.
 Какво би трябвало да знаем за бактериите в хранитеСмъртоносната мухъл
Какво би трябвало да знаем за бактериите в хранитеСмъртоносната мухъл Дори и в дребни дози приемането на афлатоксини може да аргументи съществени болести - като рак на черния дроб, или пък да докара до нарушавания в развиването на плода в майчината вътрешност. Високата централизация на този токсин провокира остро отравяне, нерядко с летален излаз.
Какво би трябвало да знаем за бактериите в хранитеСалмонелите
Какво би трябвало да знаем за бактериите в хранитеСалмонелите Бактериите от групата Salmonella живеят в стомашно-чревния тракт на доста животни. Но за индивида ентеробактериите постоянно водят до тежки болести. Строгото съблюдаване на разпоредбите за хигиена в кухнята, както и топлинната обработка (15 минути са достатъчно) най-много на месните и рибните артикули оказват помощ да се избегне разпространяването на салмонелите.
 Какво би трябвало да знаем за бактериите в хранитеОпасните чревни пръчици
Какво би трябвало да знаем за бактериите в хранитеОпасните чревни пръчици От една страна бактериите от групата Escherichia coli извършват значими функционалности в червата на индивида. Но при хората с отслабена имунна система изключително рисковият високопатогенен вариант на пръчковидните бактерии (ентерохеморагична ешерихия коли) може да провокира тежка чревна зараза.
 Какво би трябвало да знаем за бактериите в хранитеКоварната салата
Какво би трябвало да знаем за бактериите в хранитеКоварната салата Високата температура може да унищожи и салмонелите, и чревните причици. За страдание обаче бактерии има освен в продуктите от скотски генезис, само че и в зеленчуците. Преди приложимост марулите, краставиците и всички останали зеленчуци би трябвало деликатно да се измият с топла вода. Важно е да се употребяват разнообразни ножове за зеленчуци и месо. Това оказва помощ за понижаване на риска от болест.
 Какво би трябвало да знаем за бактериите в хранитеЛистериите
Какво би трябвало да знаем за бактериите в хранитеЛистериите Пръчковидните бактерии от групата Listeria са известни със способността си да се приспособяват съвършено. Те в действителност са на всички места, в това число в питателните артикули. В организма на индивида те са способни да провокират заразяване на кръвта или менингит (възпаление на кората на основния мозък). Листериите могат да бъдат победени посредством термична обработка - на 70 градуса за минимум 10 минути.
 Какво би трябвало да знаем за бактериите в хранитеНоровирусът
Какво би трябвало да знаем за бактериите в хранитеНоровирусът Вирусът Норовирус или Норфолк от групата на норовирусите доста постоянно е провинен за разпространяването на " стомашното разстройство " с гадене, повръщане и диария. Вирусът може да живее до 12 дни по зеленчуците и месните артикули. Борбата с него се води още веднъж посредством термичната обработка и дезинфекцията на ръцете.
 Какво би трябвало да знаем за бактериите в хранитеЧистите ръце - залог за здраве
Какво би трябвало да знаем за бактериите в хранитеЧистите ръце - залог за здраве Хранителните артикули влизат в прикосновение с микробите още до момента в който се обработват. Най-вече в личната кухня. Затова спазването на хигиената е най-хубавият метод за битката с бактериите и вирусите. Най-важното е ръцете да бъдат измити деликатно със сапун, преди да се пристъпи към приготвянето на храната.
 Какво би трябвало да знаем за бактериите в хранитеЗлатните правила на кухненската хигиена
Какво би трябвало да знаем за бактериите в хранитеЗлатните правила на кухненската хигиена След като един път сте размразили артикули, не трябва да ги замразявате отначало. За рязането на месото, рибата и зеленчуците би трябвало да се употребяват разнообразни дъски - по този начин може да се предотврати преместването на бактериите към продуктите, които не изискват термична обработка. Месото и рибата би трябвало да се готвят не по-малко от 10 минути (на не по-малко от 70 градуса) и би трябвало да се изяждат още същия ден!
Автор: Инга Ванер, София Вагнер
Източник: dw.com

КОМЕНТАРИ





